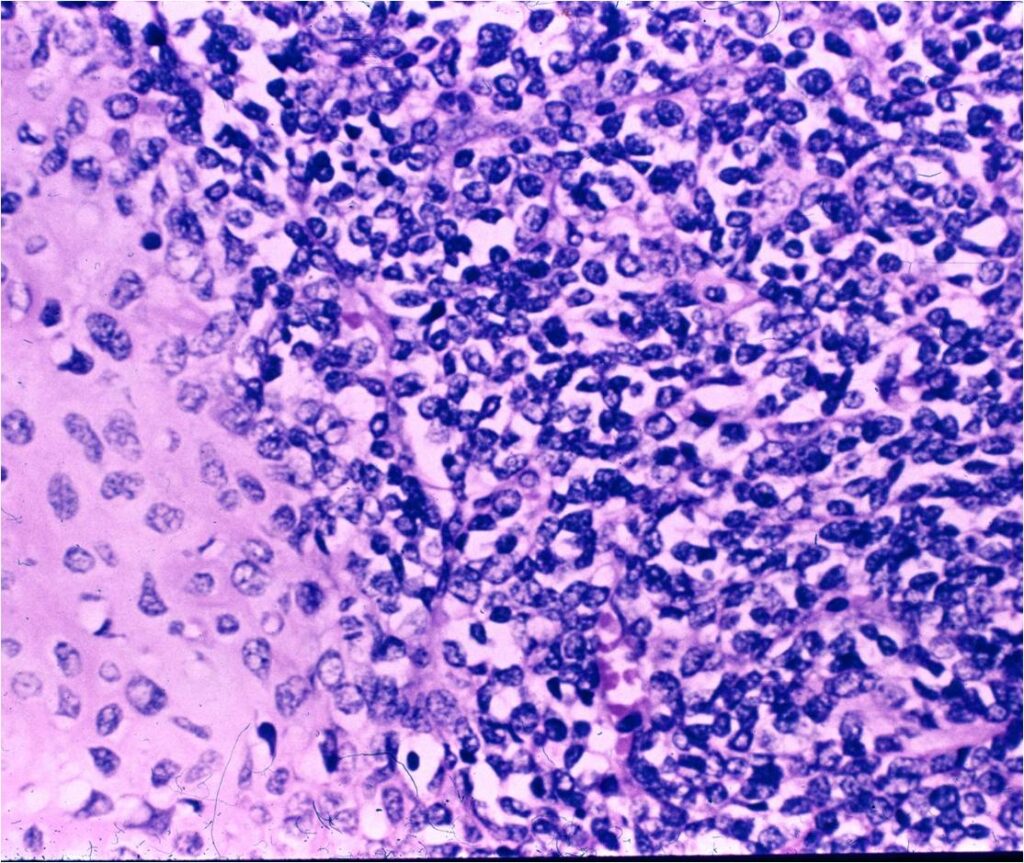

General Information
- High grade malignant, cartilage-forming tumor
- Comprised primarily of noncartilaginous small, round, oval, or spindle shaped cells with islands of malignant cartilage dispersed throughout noncartilaginous component of tumor
- Osteoid may be present as well
- Tumor frequently has a hemangiopericytoma-like appearance
- Metastasizes to the lungs and lymph nodes
- May have chondroid matrix calcification
Clinical Presentation
Signs/Symptoms:
- Pain and occasionally swelling
- ~ 1/3 of patients are symptomatic for more than 1 year
Prevalence:
- ~2% of all chondrosarcomas
- No sexual or racial predilection
Age:
- All ages
- Predominantly affects those between the ages of 10 and 40
Sites:
- Arises in bone and soft tissue (1/3 of cases arise from soft tissue)
- Favors the femur, ribs, spine, maxilla, mandible, and pelvis
- Other long tubular bones and phalanges may also be affected
Radiographic Presentation
- Aggressive motheaten to permeative lesion
- Indistinct border in most cases
- Osseous destruction with a soft tissue component
- Chondroid matrix calcification may be present (60-70% of cases)
- Soft tissue mass










Gross Pathology
- Gross appearance is variable
- Ranging from soft to firm
- Gray to pink
- Occasionally have a faintly lobulated pattern
- Grossly obvious cartilage is rarely visualized



Microscopic Pathology
- Neoplastic cells may be small, round, oval, or spindle shaped
- Undifferentiated mesenchymal cells similar to Ewing sarcoma
- Low grade islands of cartilage scattered throughout the mesenchymal cells
- Usually only a small part of lesion
- Cytologically low grade
- Usually sharply demarcated from surrounding stroma
- Stain S-100 positive
- Cells within cartilage
- Tend to have round or ovoid nuclei
- Lacunae are poorly formed
- May contain islands of collagen resembling osteoid
- Lesions are vascular and often have large, anastomosing vessels that impart hemangiopericytoma-like pattern

(Right Arrow) Cartilaginous Component
Differential Diagnosis
- Ewing Sarcoma
- Small Cell Osteosarcoma
- Dedifferentiated Chondrosarcoma
Biological Behavior
- Locally aggressive
- Cortical destruction in approximately half of cases
- Extension of tumor into adjacent soft tissues
- High metastatic and local recurrence rates
- Metastasizes primarily to lungs, other bones, lymph nodes and viscera
- Metastases may not appear for over 5 years after treatment
- Over 70% mortality
Treatment & Prognosis
- Most patients are treated with a combination of surgery and chemotherapy. Radiation is used in selected cases, particularly extraskeletal mesenchymal chondrosarcomas
- Wide/Radical limb sparing surgery whenever feasible (most cases)
- Amputation for very large or unresectable tumors






